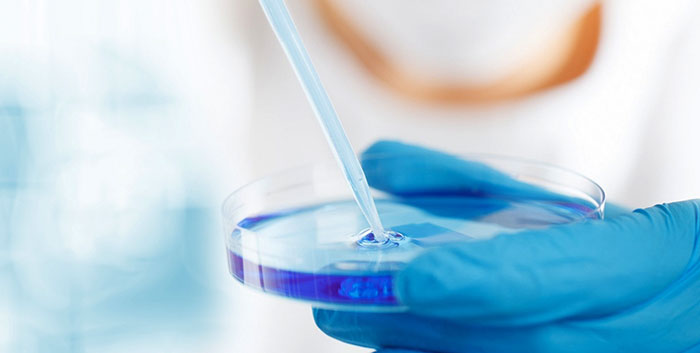

ABOUT US
公司簡介
深圳市云帆興燁科技有限公司(簡稱云帆興燁)是一家專業(yè)從事儀器儀表產(chǎn)品的綜合性服務(wù)公司。公司于2004年成立,目前已經(jīng)成為國內(nèi)知名儀器品牌代理商、系統(tǒng)集成商和綜合測試服務(wù)商。公司業(yè)務(wù)分為電子測試儀器,化學(xué)材料分析儀器,AI服務(wù)器等。
云帆興燁與美國是德(Keysight)、美國力科(LeCroy)、英國思博倫(Spirent)、美國泰克(Tektronix)、美國科學(xué)儀器公司(STI)、美國國家儀器(NI)、日本吹田(SUITA)、德國斯派克(SPECTRO)等著名儀器制造商在中國區(qū)有著廣泛深入的合作。

公司總部位于深圳市南山區(qū)西麗街道松坪山社區(qū)高新北二道16號清溢光電大樓517,在北京、上海、香港、蘇州、廈門、西安等地設(shè)有分支機(jī)構(gòu),員工人數(shù)50多人。通過與分銷伙伴的合作,擁有覆蓋全國的服務(wù)網(wǎng)絡(luò)。云帆興燁擁有一批技術(shù)型的銷售工程師和專業(yè)的售后隊伍,在多年的發(fā)展中積累了大量的案例和經(jīng)驗,能夠給客戶提供迅速、完善、專業(yè)的服務(wù)。長風(fēng)破浪會有時,直掛云帆濟(jì)滄海,云帆興燁將通過不懈的努力,繼續(xù)專注于為客戶提供分析測試解決方案,和客戶一起成功!
